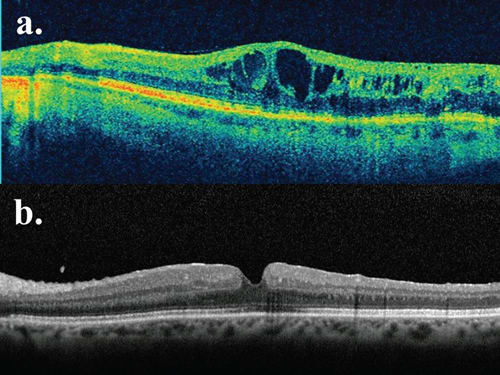

Succeeding with Combination Therapy for DME
Treatment options must be tailored to the individual patient.
John D. Pitcher, III, MD • Jean-Pierre Hubschman, MD
Diabetic macular edema continues to be a common cause of vision loss and decreased vision-related quality of life (VRQoL) in working-aged Americans.1,2 Both vision and VRQoL may be modified by treatment,3 and new modalities provide the flexibility to customize management for the patient's individual needs. Pharmacotherapy, photocoagulation and vitreoretinal surgery are some of the tools that can be used to create a treatment algorithm for DME.
The optimization of systemic factors that may contribute to ongoing damage to the retinal vasculature is essential to successful outcomes in managing DME. The Diabetes Control and Complications Trial demonstrated that intensive glycemic control provides hazard reduction in retinopathy progression of 79% at four years and 53% at 10 years.4 Data from the Early Treatment Diabetic Retinopathy Study suggest that lipid lowering may decrease hard exudate formation and associated visual loss, as well as decreasing the overall risk of cardiovascular mortality.5
Recent population-based, cross-sectional studies have also identified a relationship between high serum total cholesterol and clinically significant macular edema. In the United Kingdom Prospective Diabetes Study Group, patients with tight blood pressure control (10 mm Hg lower systolic pressure) experienced a 34% reduction in the risk of worsening retinopathy.7 The glitazones, a class of oral medications used to treat type 2 diabetes mellitus, have been implicated as a cause of macular edema, and cessation may result in rapid improvement in visual acuity.8 Each office visit represents an opportunity to counsel patients and communicate with their internists to help decrease retinal vascular complications through improved metabolic control.
RECENT COMBINATION THERAPY DATA
For over two decades, focal macular laser (FML) photocoagulation dominated as standard of care for DME. The ETDRS outcomes focused on the preservation of vision and found a 50% reduction in the likelihood of severe vision loss with grid-style FML.9 The Diabetic Retinopathy Clinical Research Network more recently reported a 10-letter gain in nearly one-third of patients treated with laser, but 19% experienced progressive visual loss.10
In 2010, the READ-2 study using ranibizumab re ported equivalent visual outcomes of intravitreal anti-VEGF to FML at two-year follow-up, and six-month gains were experienced by the injection-only group. Supplementing with FML reduced the number of injections given by half.11
This year, the RESTORE study demonstrated superior gains in best-corrected visual acuity at one year with ranibizumab with or without laser vs laser monotherapy.12 In contrast to READ-2, the authors found greater reduction in foveal thickness in the anti-VEGF groups, as well as better VRQoL. The number of total injections over the year for the injection only group was 7.1 vs 4.8 in the combination therapy group.
In addition, the randomized, double-masked, shamcontrolled, 36-month phase 3 trials of ranibizumab for DME (RISE and RIDE) suggest that anti-VEGF therapy is effective in improving vision vs placebo, as both studies met their primary endpoints (15 ETDRS letter gain from baseline).
DA VINCI, the phase 2 study of aflibercept (now Eylea, formerly VEGF Trap-Eye) for DME with permitted laser rescue, also showed promising visual gains at 12 months.13 Although intravitreal steroids have the added benefit of targeting the inflammatory component of DME, the clinical benefits have been less impressive. They may be an appropriate option with or without FML in nonresponders who are pseudophakic or those who have had successful filtration surgery to control intraocular pressure (DRCR.net protocol 1, phase 3 FAME trial, phase 3 PLACID trial).14-16
Randomized trials have provided valuable insight into our understanding of how to manage DME. In most studies, all patients with edema are combined to achieve large enough groups to achieve statistically signif icant results. However, not all DME is created equally. Identifying the underlying pathophysiologic mechanism is crucial to successful therapeutic intervention. Vascular permeability, inflammation, traction, ischemia and neuronal changes can all contribute to vision loss. At the initial examination, high mag nification or contact lens biomicroscopy, fluorescein angiography (FA), and spectraldomain optical coherence tomography can be used to subclassify DME to guide treatment (Figure 1).

Figure 1. An algorithm for the management of diabetic macular edema.
SUBTYPES OF DME
DME often occurs in association with a circinate ring of hard exudates surrounding microaneurysms (Figure 2). This subtype is focal diabetic macular edema (FDME), and a localized vascular abnormality is the primary pathologic feature. If vision-threatening, our preference is to treat immediately with focal macular photocoagulation (occasionally preceded by intravitreal anti-VEGF injection, depending on severity), titrated to achieve a color change in the targeted leaking aneurysms.

Figure 2. Circinate hard exudates in a diabetic patient associated with retinal thickening, surrounding a cluster of central microaneurysms.
Diffuse diabetic macular edema (DDME) is a different disease process that usually proves more difficult to manage. Combination therapy is particularly helpful in DDME to achieve both rapid and longstanding benefits for the patient. The majority of the macula is frequently involved, and cystoid macular edema and even serous macular detachment may be prominent features (Figure 3).

Figure 3. Diffuse diabetic macular edema (DDME); macular view of ultra-widefield fluorescein angiogram (a) and SDOCT (b).
In our practice, these patients typically receive intravitreal anti-VEGF therapy followed by re-evaluation in one month using SD-OCT. Although no drugs are FDAapproved for DME, bevacizumab tends to be our initial choice to maximize practitioner convenience and minimize patient cost. Pharmacotherapy is effective, but no definitive dosing guidelines exist. We repeat injections every four to six weeks (as in READ-2 and RESOLVE), based on functional (visual acuity) and structural (SD-OCT) response, as well as the patient's subjective assessment.
The DRCR.net investigators found evidence that prompt or deferred laser following intravitreal anti-VEGF injection results in greater visual acuity gains over controls.14 To help reduce the burden of monthly injections in cases with multiple areas of leakage on FA, we frequently perform modified ETDRS-style macular grid photocoagulation within two weeks after an anti-VEGF treatment. Our parameters vary according to the status of each patient's media and fundus pigmentation and are titrated to obtain a minimally visible burn (typically 100-μm spot size, 10-millisecond pulse duration, 225-mW power and 29 J/cm fluence). Such settings are of shorter duration than those in recent DRCR.net cohorts but have similar visual outcomes, with the benefit of higher spatial localization of the lesion with less expansion over time.17
Recently, we described the peripheral angiographic features of retinal vein occlusions and their association with vision-threatening complications using ultra-widefield fluorescein angiography (UWFFA). A high level of untreated nonperfusion, or elevated “ischemic index,” is correlated with macular edema, presumably through a VEGF-mediated mechanism.18 We have found similar trends in DME and use UWFFA to evaluate our patients and treat those with increased ischemic indices via “targeted” retinal photocoagulation (Figure 4).

Figure 4. Ultra-widefield fluorescein angiography of a patient with DME and areas of untreated midperipheral nonperfusion (arrows).
An abnormal vitreomacular interface may be responsible for increased vascular permeability in a subset of patients with DDME. Reduced edema can occur after spontaneous posterior vitreous detachment20 and increased retinal oxygenation following surgical removal of the vitreous. These observations have led to evaluations of the efficacy of pars plana vitrectomy for DME.
The DRCR.net investigators organized a prospective cohort study of 87 eyes with vision worse than 20/63 due to DME with vitreomacular traction.21 Median OCT central foveal thickness decreased by an average of 160 μm, with at least a 50% reduction in 68% of patients. Factors associated with better outcomes included worse visual acuity and retinal thickening at baseline, epiretinal membrane (ERM) and internal limiting membrane (ILM) removal, and OCT evidence of vitreoretinal abnormalities.
Based on these data, patients in our practice who have these characteristics (Figure 5) are offered PPV with ERM and ILM peeling, usually after failure of pharmacotherapy. It should be noted that subsequent intravitreal injections in the postvitrectomized eye will be under augmented pharmacokinetics, with faster clearance and shorter half-life of the drug. Extended release devices may overcome this obstacle. In CHAMPLAIN, an open-label, phase 3b trial of the dexamethasone implant for DME in vitrectomized eyes, nearly one-third of patients experienced a two-line improvement in visual acuity at week 13.22
Figure 5. SD-OCT of a patient with 20/80 vision and diffuse DME exacerbated by an epiretinal membrane, who failed multiple intravitreal anti-VEGF treatments (a). Two months after PPV with induction of a posterior vitreous detachment, ERM/ILM peeling and bevacizumab injection, his vision improved to 20/40 with restoration of near-normal foveal architecture (b).
CONCLUSION
Diabetic macular edema can be a difficult but rewarding entity to treat. It requires thoughtful consideration of the anatomic features through careful examination, aided by retinal imaging techniques. Systemic and social factors may even play a role (eg, using intravitreal steroids in a patient with recent thromboembolic events or the inability to follow up for more frequent dosing of other anti-VEGF agents). No patients present identically, and combining pharmacotherapy, macular and peripheral targeted photo coagulation, and surgical techniques are often necessary to achieve good outcomes and satisfied patients. RP
REFERENCES
1. Klein R, Knudtson MD, Lee KE, et al. The Wisconsin Epidemiologic Study of Diabetic Retinopathy: XVIII. The 14-year incidence and progression of diabetic retinopathy and associated risk factors in type 1 diabetes. Ophthalmology. 1998;105:1801-1815.
2. Hariprasad SM, Mieler WF, Grassi M, et al. Vision-related quality of life in patients with diabetic macular oedema. Br J Ophthalmol. 2008;92:89-92.
3. Tranos PG, Topouzis F, Stangos NT, et al. Effect of laser photocoagulation treatment for diabetic macular oedema on patient's vision-related quality of life. Curr Eye Res. 2004;29:41-49.
4. White NH, Sun W, Cleary PA, et al. Prolonged effect of intensive therapy on the risk of retinopathy complications in patients with type 1 diabetes: 10 years after the Diabetes Control and Complications Trial. Arch Ophthalmol. 2008; 126:1707-1715.
5. Chew EY, Klein ML, Ferris FL 3rd, Remaley NA, Murphy RP, Chantry K,Hoogwerf BJ, Miller D. Association of elevated serum lipid levels with retinal hard exudate in diabetic retinopathy. Early Treatment Diabetic Retinopathy Study (ETDRS) Report 22. Arch Ophthalmol. 1996:114:1079-1084.
6. Raman R, Rani PK, Kulothungan V, Rachepalle SR, Kumaramanickavel G, Sharma T. Influence of serum lipids on clinically significant versus nonclinically significant macular edema: SN-DREAMS Report number 13. Ophthalmology. 2010;117:766-772.
7. Tight blood pressure control and risk of macrovascular and microvascular complications in type 2 diabetes: UKPDS 38. UK Prospective Diabetes Study Group. BMJ 1998:12;317:703-713.
8. Ryan EH Jr., Han DP, Ramsay RC, Cantrill HL, Bennett SR, Dev S, Williams DF.Di abetic macular edema associated with glitazone use. Retina. 2006;26:562570.
9. Photocoagulation for diabetic macular edema. Early Treatment Diabetic Retinopathy Study report number 1. Early Treatment Diabetic Retinopathy Study research group. Arch Ophthalmol. 1985;103:1796-1806.
10. Diabetic Retinopathy Clinical Research Network. Factors associated with improvement and worsening of visual acuity 2 years after focal/grid photocoagulation for diabetic macular edema. Ophthalmology. 2010;117:946-953.
11. The READ-2 Study Group. Two-year outcomes of ranibizumab for edema of the macula in diabetes (READ-2) study. Ophthalmology. 2010;117:2146-2151.
12. The RESTORE Study Group. The RESTORE study: Ranibizumab monotherapy or combined with laser versus laser monotherapy for diabetic macular edema. Ophthalmology. 2011;118:615-625.
13. Do DV. Anti-VEGF therapy for DME: The DaVinci Study. Paper presented at: Angiogenesis, exudation and degeneration 2011; Miami, FL; Febuary 12, 2011.
14. Diabetic Retinopathy Clinical Research Network. Expanded 2-year follow-up of ranibizumab plus prompt or deferred laser or triamcinolone plus prompt laser for diabetic macular edema. Ophthalmology. 2011;118:609-614.
15. Pearson PA, Comstock TL, Ip M, et al. Fluocinolone acetonide intravitreal implant for diabetic macular edema: a 3-year multicenter, randomized, controlled clinical trial. Ophthalmology. 2011;118:1580-1587.
16. Safety and efficacy of a new treatment in combination with laser for diabetic macular edema. ClinicalTrials.gov Web site. http://clinicaltrials.gov/ct2/show/NCT00464685. Accessed September 8, 2011.
17. Jain A, Collen J, Kaines A, Hubschman JP, Schwartz S. Short-Duration focal pattern grid macular photocoagulation for diabetic macular edema: four-month outcomes. Retina. 2010;30:1622-1626.
18. Prasad PS, Oliver SC, Coffee RE, Hubschman JP, Schwartz SD. Ultra wide-field angiographic characteristics of branch retinal and hemicentral retinal vein occlusion. Ophthalmology. 2010;117:780-784.
19. Oliver SC, Schwartz SD. Peripheral vessel leakage (PVL): A new angiographic finding in diabetic retinopathy identified with ultra wide-field fluorescein angiography. Semin Ophthalmol. 2010;25:27-33
20. Hikichi T, Fujio N, Akiba Y, et al. Association between the short-term natural history of diabetic macular edema and the vitreomacular relationship in type II diabetes mellitus. Ophthalmology. 1997;104:473-478.
21. Diabetic Retinopathy Clinical Research Network. Factors associated with visual acuity outcomes after vitrectomy for diabetic macular edema. Retina. 2010;30:1488-1495.
22. Boyer DS, Faber D, Gupta S, et al; for the Oxurdex CHAMPLAIN Study Group. Dexamethasone intravitreal implant for treatment of diabetic macular edema in vitrectomized patients. Retina. 2011 Apr 9 [Epub ahead of print].
| John D. Pitcher, III, MD, is a resident at the Jules Stein Eye Institute, David Geffen School of Medicine at the University of California, Los Angeles. Jean-Pierre Hubschman, MD, is on the faculty of the Retina Division at Jules Stein. Neither author reports any financial interest in any products mentioned in this article. Dr. Pitcher can be reached via e-mail at johndpitcher@gmail.com. |








